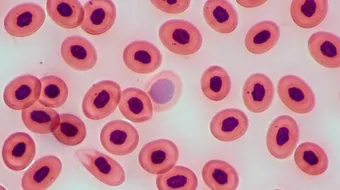
ارتفاع عدد الصفائح الدموية

ارتفاع عدد الصفائح الدموية
ارتفاع عدد الصفائح الدمويةتلعب الصفائح الدمويّة دوراً مهمّاً في عمليّة تخثّر الدم، ويُطلق على ارتفاع عدد الصفائح الدمويّة عن الحدّ الطبيعيّ مصطلح كثرة الصفيحات

ارتفاع عدد الصفائح الدموية
تلعب الصفائح الدمويّة دوراً مهمّاً في عمليّة تخثّر الدم، ويُطلق على ارتفاع عدد الصفائح الدمويّة عن الحدّ الطبيعيّ مصطلح كثرة الصفيحات (بالإنجليزية: Thrombocytosis)، حيثُ يتمّ إنتاج كميّات كبيرة من صفائح الدم ضمن نقيّ العظام، ويُطلق مصطلح كثرة الصفيحات الأوليّ في حال عدم تحديد المسبّب الرئيسيّ لارتفاع عدد الصفائح الدمويّة، أمّا بالنسبة للحالات الناجمة أسباب أخرى مثل العدوى فتُعرَف بكثرة الصفيحات الثانويّ.[1]
أعراض ارتفاع عدد الصفائح الدموية
لا يصاحب ارتفاع عدد الصفائح الدمويّة في الدم أيّة أعراض واضحة عالشخص المصاب في العديد من الحالات، وفي حال ظهور الأعراض فقد تتضمّن النزيف الداخليّ في المعدة والأمعاء، ونزيف الفم واللثة، وظهور الكدمات على الجلد، كما قد يعاني بعض الأشخاص من احمرار الأطراف المؤلم (بالإنجليزية: Erythromelalgia) في حال الإصابة بكثرة الصفيحات الأوليّ، ويصاحب هذه الحالة ألم، واحمرار، وانتفاخ في الأطراف.[2]
أسباب ارتفاع عدد الصفائح الدموية
لا يمكن تحديد المسبّب الرئيسيّ لبعض حالات كثرة الصفيحات الأوليّ، ولكن في بعض الحالات النادرة قد تكون المشكلة ناجمة عن بعض الاضطرابات الوراثيّة، أمّا بالنسبة لكثرة الصفيحات الثانويّ فقد يكون ناجماً عن عدد من الأسباب والمشاكل الصحيّة المختلفة، نذكر منها ما يأتي:[3]
- فقر الدم الناجم عن عوز الحديد.
- بعض أمراض العدوى، والأمراض الالتهابيّة مثل مرض السلّ، وأمراض الأمعاء الالتهابيّة.
- فقر الدم الانحلاليّ (بالإنجليزية: Hemolytic anemia).
- استئصال الطحال.
- بعض أنواع الأدوية.
علاج ارتفاع عدد الصفائح الدموية
يعتمد علاج ارتفاع الصفائح الدمويّة على المسبّب الرئيسيّ للارتفاع، وفي العديد من الحالات لا يحتاج الشخص للحصول على العلاج ويكتفي الطبيب بمراقبة عدد الصفائح من خلال إجراء بعض التحاليل الدوريّة، وقد يقوم الطبيب بوصف جرعة صغيرة من دواء الأسبرين (بالإنجليزية: Aspirin) للوقاية من تخثّر الدم، وفي الحالات الشديد يمكن إجراء عمليّة فصادة الصفيحات (بالإنجليزية: Plateletpheresis) للعمل على خفض عدد الصفيحات الدمويّة بسرعة، أمّا بالنسبة للأشخاص الذين يعانون من كثرة الصفيحات الأوليّ فقد يحتاجون إلى استخدام بعض الأدوية مدى الحياة للعمل على تثبيط إنتاج الصفائح الدمويّة مثل دواء أناغريليد (بالإنجليزية: Anagrelide)، ودواء هيدروكسي يوريا (بالإنجليزية: Hydroxyurea).[4]
المراجع
- ↑ "Thrombocytosis", www.mayoclinic.org,13-9-2018، Retrieved 7-5-2019. Edited.
- ↑ "Thrombocytosis", my.clevelandclinic.org, Retrieved 7-5-2019. Edited.
- ↑ "Thrombocythemia and Thrombocytosis", www.nhlbi.nih.gov, Retrieved 7-5-2019. Edited.
- ↑ "Thrombocytosis: Management and Treatment", my.clevelandclinic.org, Retrieved 7-5-2019. Edited.
المقال السابق: طريقة إنشاء ياهو
المقال التالي: ما هو تحليل كيمياء الدم
ارتفاع عدد الصفائح الدموية: رأيكم يهمنا
0.0 / 5
0 تقييم
